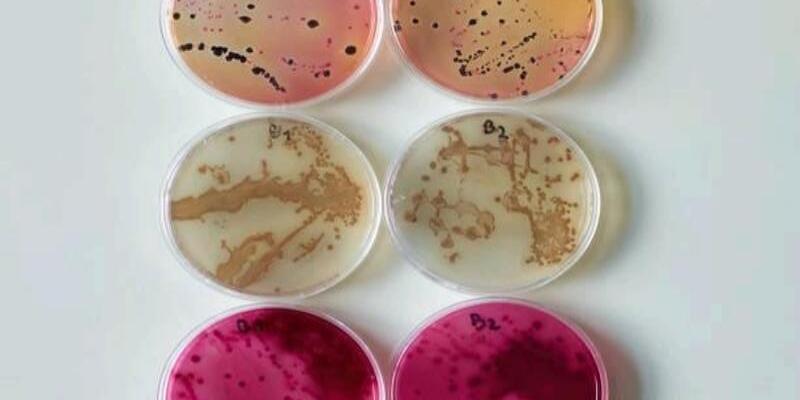

How Red Algae Is Making Waves In The Beauty Industry
The cosmetic sector is perpetually seeking natural elements endowed with diverse advantages, and red algae has emerged as an eminent contender. Celebrated for its luxuriant nutrient compendium, red algae skincare benefits have been recognized, particularly for its anti-ageing capabilities. This treatise elucidates the metamorphic influence of red algae within the beauty domain, meticulously scrutinizing its diverse benefits and the burgeoning compendium of red algae beauty products.
Comprehending Red Algae
Red algae, scientifically classified as Rhodophyta, is a marine botanical predominantly found in aqueous milieus. It is replete with a cornucopia of nutrients, encompassing a veritable panoply of vitamins, minerals, and antioxidants. Red algae's sui generis biochemical constitution renders it an exceptionally efficacious constituent in skincare formulations. The red algae skincare benefits are multitudinous, conferring formidable fortification against environmental aggressors, augmenting hydric retention, and fostering holistic cutaneous vitality.
The Anti-Aging Virtuosity Of Red Algae
One of the most distinguished benefits of red algae skin care is its unparalleled anti-ageing attributes. The bioactive constituents intrinsic to red algae, such as peptides and polysaccharides, potentiate collagen oogenesis and enhance dermal turgor. This endows red algae for anti-ageing with considerable acclaim among skincare cognoscenti, particularly that intent on perpetuating a youthful visage.
Paramount Anti-Aging Advantages:
Red algae for anti-ageing efficaciously attenuates the prominence of fine lines and rhytides.
It fortifies dermal resilience, imbuing the skin with a more firm and unified aspect.
The antioxidative properties inherent in red algae act as a bulwark against free radical-induced degenerescence, a predominant etiological factor in premature ageing.
Rigorous empirical investigations corroborate red algae's efficacy as an anti-ageing agent, cementing its status as a coveted constituent in a panoply of premier red algae beauty products.

Hydration And Moisturization With Red Algae
Another benefit of cardinal red algae skin care is its prodigious capacity for hydration and moisturization. Red algae are imbued with polysaccharides, exhibiting an extraordinary moisture retention propensity. This ensures sustained hydration of the epidermis, rendering it supple and velutinous throughout the day.
Hydration Benefits:
Red algae beauty products excel in hygroscopic retention, thwarting dermal desiccation.
The hydrating potency of red algae renders it indispensable for individuals suffering from xerosis or heightened cutaneous sensibility.
Perpetual utilization of red algae beauty products enhances the overall integumentary texture and aesthetic appeal.
Red Algae As A Dermal Protector
Beyond its anti-ageing and hydrating virtues, red algae's skincare benefits extend to its role as a formidable dermal shield. Environmental perturbations, including toxic pollutants and ultraviolet radiation, can precipitate profound dermal damage. However, red algae's antioxidative and bioactive constituents endow the skin with a protective aegis against deleterious forces.
Dermal Protection Advantages:
Red algae skincare benefits encompass safeguarding the skin from ultraviolet-induced detriment.
The antioxidative properties in red algae neutralize reactive oxygen species, thereby mitigating oxidative stress on the integument.
Red algae beauty products establish a natural barrier against environmental contaminants.
The Ascendant Popularity Of Red Algae Beauty Products
The burgeoning ascendancy of red algae beauty products is a testament to its manifold skincare benefits. Red algae are adroitly integrated into various skincare formulations, from serums and moisturizers to masks and cleansers. Their versatility ensures their compatibility with a broad spectrum of cutaneous phenotypes, further amplifying their demand.
Prominent Red Algae Beauty Products:
Red algae for anti-ageing serums designed to mitigate the appearance of rhytides.
Moisturizers incorporating red algae that proffer enduring hydric retention.
Cleansers imbued with red algae that cleanse the epidermis while preserving its intrinsic oils.
Incorporating Red Algae Into Your Skincare Regimen
Incorporating red algae beauty products into your skincare regimen can yield prodigious advantages. Whether your objective is to counteract the signs of senescence, augment dermal hydration, or fortify your skin against environmental onslaughts, red algae offers a productive solution.
Steps To Incorporate:
1. Commence with red algae for anti-ageing serum to target fine lines and rhytides.
2. Follow with a moisturizer infused with red algae for enhanced hydric retention and protection.
3. Employ a red algae-based cleanser to maintain dermal purity without depleting its intrinsic oils.
4. Consider integrating a red algae mask weekly for an intensive reparative treatment.
Red Algae’s Role In Bolstering The Cutaneous Barrier Function
Red algae are lauded not solely for their anti-ageing faculties but also for their ability to bolster the integumentary barrier. This tenacious marine phyto component is replete with sulfated polysaccharides, pivotal in reinforcing the cutaneous lipid matrix and augmenting barrier functionality. This characteristic renders red algae skincare benefits indispensable for those intent on safeguarding their dermis from transepidermal water loss (TEWL) and exogenous stressors.
Benefits Of Augmented Barrier Function:
Red algae for anti-ageing are instrumental in preserving the skin's structural cohesion and thwarting incipient signs of senescence.
The bioactive moieties in red algae fortify the skin’s immunological resistance against irritants and allergens.
Sustained application of red algae beauty products can culminate in visibly fortified, more resilient integumentary health.
Red Algae’s Detoxification Efficacy In Dermatological Applications
Another salient facet of red algae skin care benefits is its detoxification efficacy. The algal bioactives, including carrageenans and phycoerythrins, are renowned for their chelating capabilities. They bind with heavy metals and pollutants, facilitating their excretion from the dermal layers. Detoxification is paramount for sustaining pellucid, luminous skin, making red algae beauty products particularly advantageous for urban denizens subjected to environmental contaminants.
Detoxification Advantages:
Red algae beauty products efficiently expurgate the skin of xenobiotic impurities, mitigating the incidence of acneiform eruptions and dermatitic conditions.
The detoxification attributes of red algae can decelerate the cutaneous senescence process induced by urban pollution.
Integrating red algae into your regimen for anti-ageing products can revitalize dull, tired skin by expelling cutaneous toxins.
Red Algae’s Efficacy In Ameliorating Hyperchromia And Achieving Even Complexion
Cutaneous hypochromia and dyschromia are prevalent dermatological concerns that can be effectively alleviated through red algae skincare benefits. Red algae are replete with mycosporine-like amino acids (MAAs), which exhibit potent photoprotective properties. These MAAs attenuate melanin biosynthesis in response to ultraviolet exposure, positioning red algae beauty products as quintessential for those pursuing a more homogeneous complexion.
Benefits For Hypochromia Mitigation:
Red algae for anti-ageing is also instrumental in reducing solar lentigines and photodamage-induced hyperpigmentation.
The cutaneous luminosity-enhancing effects of red algae contribute to a more radiant dermal appearance.
Persistent utilization of red algae beauty products can result in a perceptible diminution of dyschromia and cutaneous discolouration.
Conclusion
Red algae has unequivocally solidified its prominence within the beauty industry. With its extensive panoply of benefits—from anti-ageing to hydration and dermal protection—it is no wonder red algae beauty products are witnessing unprecedented popularity. Whether you aim to attenuate the signs of senescence, sustain optimal dermal hydration, or shield your skin from environmental stressors, red algae provide a natural and potent solution. The benefits of red algae skincare are indisputable, rendering them an indispensable constituent in contemporary skincare regimens. By incorporating red algae for anti-ageing and other red algae products into your daily routine, you can revel in the enduring advantages of this extraordinary marine botanical.





